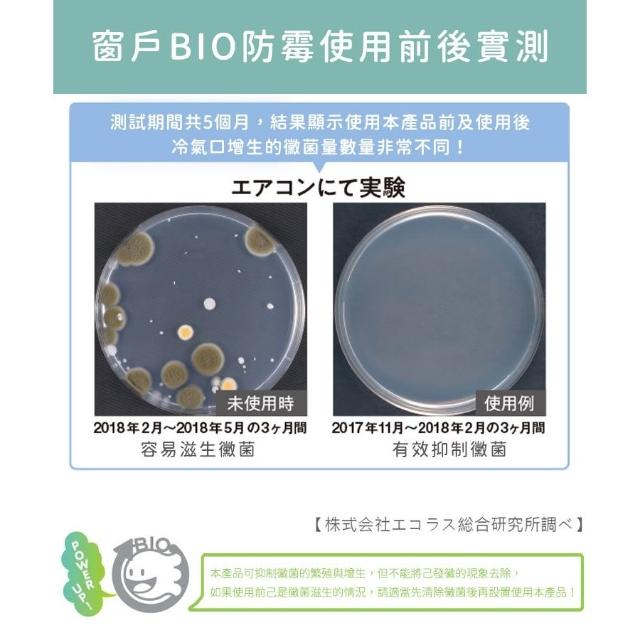

「長效防霉除臭,窗戶更清新」
免運券
COGIT日本COGIT 日本製BIO長效窗戶專用除臭防霉除濕貼|窗戶除濕貼|防霉除臭貼|BIO長效除濕貼|窗戶防霉貼
- 品號:TP00074590000505
- BIO長效除濕技術。
- 有效防止霉菌與異味。
- 簡便貼合,維持室內乾燥與清新。
促銷價
$218
元
品牌名稱
COGIT
結帳方式
信用卡 \ 貨到付款 \ ATM
分期
配送方式
運費$45,訂單滿$290 免運費
運費$65,訂單滿$690 免運費
數量
折價券
查看可使用的折價券 / 免運券 / 抵用券
保固資訊
安裝與否
商品評價

退換貨須知
- 商品到貨享十天猶豫期之權益(注意!猶豫期非試用期),依法辦理退貨商品必須是全新狀態且包裝完整(包含主機、附件、內外包裝、隨機文件、贈品等)。如商品一經拆封或使用致商品價值受損(例僅得以福利品出售),商店將向消費者就商品一部或全部價值減損收取適當之費用(回復原狀、整新費),否則將影響退貨的權限。請先確認商品正確、外觀可接受,再行開機/使用,以免影響您的權利,祝您購物順心。
- 為保障您購物權益,開箱過程請全程錄影;如有問題請使用APP透過「問問」與商店聯繫,祝您購物愉快。
- 個人衛生用品除商品本身有瑕疵外,未拆封商品仍享有十天猶豫期之退貨權利。但已拆封 (如剪標、下水等情形…),依據《通訊交易解除權合理例外情事適用準則》第二條規定,商店無法接受退換貨。
- 個人衛生用品:泛指與肌膚及人體私密處接觸之商品,例如:內衣褲(含隱形胸罩、胸扥、胸貼、透明肩帶、水餃墊/美胸墊、襯裙)、塑身衣(含馬甲、束褲、束腿、腰夾、內搭)、泳裝、襪子、紙尿褲、牙刷….等。
運送服務
- 商店所提供的產品配送區域範圍目前僅限台灣本島。
- 商品之實際配貨日期、退換貨日期,依我們向您另行通知之內容為準。
- 針對大型商品(包括:大型家電、家具床墊、健身按摩器材、車類...等),商店將於完成收款確認後,一天內〈不含例假日〉將會有專人與您確認相關配送細節等的聯繫。偏遠地區、樓層費及其它加價費用,皆由商店於約定配送時一併告知,商店將保留出貨與否的權利。
- 依照客戶指定配送之商品(約配商品)接獲訂單逾30日您未通知出貨及受領商品,為了保障您的權益,商店得取消訂單,請客戶重新下單購買。
售後服務
- 收到商品時,請依正常程序儘速檢查商品,若商品發生新品瑕疵之情形,請至 『會員中心>訂單/退換貨』,申請退貨或使用APP透過「問問」與商店聯繫。
- 若您對於購買流程、付款方式、退貨及商品運送方式有疑問,請至『會員中心>常見問題』中查詢。
特別說明
- 本公司收到您下單(要約)後,仍需確認交易條件正確、供貨商品有庫存或服務可提供。如有無法接受訂單之異常情形,或您下單後未能完成正常付款,應視為訂單(買賣契約)全部自始不成立或失效,本公司得於合理期間內通知說明拒絕接受訂單。請您重新依需求下單訂購。
- 本公司對於所販售具遞延性之商品或服務,消費者權益均受保障。如因商店無法提供商品或服務,請與本公司聯繫辦理退貨或換成等值商品。
- 特惠商品,不適用折價券
品牌名稱:COGIT